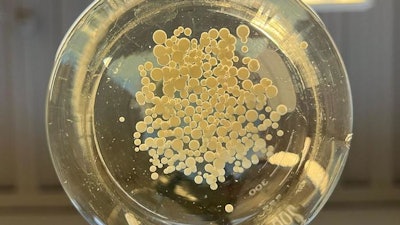

URBANA, Ill. – Creating fertilizers from organic waste can help reduce the consumption of fossil fuels and promote sustainable production. One way of doing this is through hydrothermal liquefaction (HTL), which converts biomass into biocrude oil through a high-temperature, high-pressure process. Two studies from the University of Illinois Urbana-Champaign explore the use of a fungal treatment to convert the leftover wastewater into fertilizer for agricultural crops.
“HTL uses wet biomass from organic sources such as swine manure or food waste. The process yields wastewater, called hydrothermal liquefaction aqueous phase (HTL-AP), which is usually discarded. We know it contains nutrients that can be used for fertilizer, but they are mostly in organic forms that plants can't access. HTL-AP may also contain toxic heavy metals, depending on the type of biowaste,” said co-author Paul Davidson, an associate professor in the Department of Agricultural and Biological Engineering (ABE), part of the College of Agricultural, Consumer and Environmental Sciences and The Grainger College of Engineering at Illinois.
“We explored the use of Trametes versicolor, a white-rot fungus, to break the organic nitrogen compounds into ammonia or nitrate and potentially remove toxic components. As an eco-friendly approach, T. versicolor has been explored to treat different wastewater and seems a promising candidate to treat HTL-AP,” said Vitória Leme, lead author of the first study.
Leme, then a master’s student in ABE, developed the methods to grow the fungus and add it to the wastewater. This study demonstrated that treating a solution containing 5 % HTL-AP with T. versicolor for 3 days increased nitrate and ammonia concentrations significantly.
After Leme graduated, Karla Lopez took over. She conducted the research as an undergraduate student in Engineering Technology and Management for Agricultural Systems (ETMAS), one of two undergraduate degree paths housed in ABE.
Lopez was the lead author of the second study combining the fungal treatment with a bacterial nitrification process to further convert ammonia into nitrate. The study found that simultaneous inoculation of T. versicolor and nitrifying bacteria increased nitrate concentrations in HTL-AP 17 times.
“We looked at different factors that affected the results and found the samples had the highest increases in both nitrate and ammonia when the microorganisms were subjected to water with a pH range of 6 to 7.5,” Lopez stated. “There's also evidence that the fungus is removing some of the potentially toxic compounds in the biowaste. We found the treatment produced an enzyme that has been shown to degrade toxins.”
Building on the promising results from the two studies, Davidson’s research team is now working on using the treated wastewater to grow hydroponic crops.
He said the treatment should ideally be done as close as possible to the HTL process, establishing a circular economy and reducing the need to transport heavy, wet biomass long distances.
“For example, if you are using swine manure as your wet feedstock, you could set up this whole system in close proximity to a swine farm, where there are thousands of pigs and lots of manure. You can collect the manure and run it through the HTL process, extract the wastewater, and have a separate system set up to treat the wastewater onsite. And if you’re near a swine farm, there’s probably crops nearby where you can use the treated wastewater as a fertilizer.”